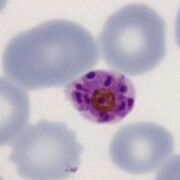
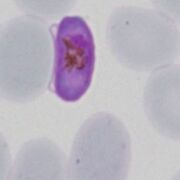
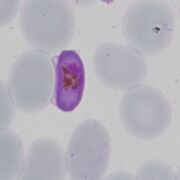

File list
This special page shows all uploaded files.
| Date | Name | Thumbnail | Size | User | Description | Versions |
|---|---|---|---|---|---|---|
| 18:42, 2 January 2025 | PFG1mag.jpg (file) |  |
40 KB | Admin | 3 | |
| 18:41, 2 January 2025 | PFGanno.jpg (file) |  |
71 KB | Admin | 3 | |
| 23:03, 22 December 2024 | Celtic cross 3.jpg (file) |  |
33 KB | Admin | 1 | |
| 23:03, 22 December 2024 | Celtic cross 2.jpg (file) |  |
33 KB | Admin | 1 | |
| 23:03, 22 December 2024 | Celtic cross 1.jpg (file) |  |
37 KB | Admin | 1 | |
| 23:02, 22 December 2024 | Bab simple 4.jpg (file) |  |
103 KB | Admin | 1 | |
| 23:02, 22 December 2024 | Bab simple 3.jpg (file) |  |
95 KB | Admin | 1 | |
| 23:02, 22 December 2024 | Bab simple 2.jpg (file) |  |
102 KB | Admin | 1 | |
| 23:02, 22 December 2024 | Bab simple 1.jpg (file) |  |
109 KB | Admin | 1 | |
| 23:01, 22 December 2024 | Bab free 2.jpg (file) |  |
118 KB | Admin | 1 | |
| 23:01, 22 December 2024 | Bab free 1.jpg (file) |  |
96 KB | Admin | 1 | |
| 23:01, 22 December 2024 | Bab complex 2.jpg (file) |  |
118 KB | Admin | 1 | |
| 23:01, 22 December 2024 | Bab complex 1.jpg (file) |  |
96 KB | Admin | 1 | |
| 18:22, 20 December 2024 | DaisyPM.jpg (file) | |
74 KB | Admin | 1 | |
| 18:20, 20 December 2024 | BasketPM.jpg (file) |  |
57 KB | Admin | 1 | |
| 18:10, 20 December 2024 | PVBa1.jpg (file) |  |
49 KB | Admin | 1 | |
| 18:10, 20 December 2024 | PMBand3.jpg (file) |  |
68 KB | Admin | 1 | |
| 18:10, 20 December 2024 | PMBand2.jpg (file) |  |
75 KB | Admin | 1 | |
| 18:09, 20 December 2024 | PMBand1.jpg (file) |  |
27 KB | Admin | 1 | |
| 18:09, 20 December 2024 | PKBand.jpg (file) |  |
26 KB | Admin | 1 | |
| 18:05, 20 December 2024 | PVcentral.jpg (file) |  |
33 KB | Admin | 1 | |
| 18:05, 20 December 2024 | POcentral.jpg (file) |  |
33 KB | Admin | 1 | |
| 18:05, 20 December 2024 | PFcentral.jpg (file) |  |
30 KB | Admin | 1 | |
| 18:05, 20 December 2024 | PMcentral.jpg (file) |  |
33 KB | Admin | 1 | |
| 15:32, 17 December 2024 | MacroPF.jpg (file) |  |
37 KB | Admin | 3 | |
| 15:29, 17 December 2024 | MicroPF.jpg (file) | |
30 KB | Admin | 2 | |
| 13:15, 17 December 2024 | MicroPV.jpg (file) |  |
46 KB | Admin | 1 | |
| 13:15, 17 December 2024 | MacroPV.jpg (file) |  |
32 KB | Admin | 1 | |
| 13:09, 17 December 2024 | Comet.jpg (file) |  |
52 KB | Admin | 1 | |
| 18:20, 12 December 2024 | Amoeboid2.jpg (file) |  |
31 KB | Admin | 1 | |
| 18:20, 12 December 2024 | Amoeboid1.jpg (file) |  |
30 KB | Admin | 1 | |
| 21:06, 10 December 2024 | MBi2.jpg (file) | |
30 KB | Admin | 1 | |
| 21:06, 10 December 2024 | MB3.jpg (file) |  |
66 KB | Admin | 1 | |
| 21:05, 10 December 2024 | MB1.jpg (file) |  |
53 KB | Admin | 1 | |
| 19:17, 6 December 2024 | 11double4.jpg (file) |  |
25 KB | Admin | 1 | |
| 19:17, 6 December 2024 | 11double3.jpg (file) |  |
28 KB | Admin | 1 | |
| 19:16, 6 December 2024 | 11double2.jpg (file) |  |
35 KB | Admin | 1 | |
| 19:16, 6 December 2024 | 11double1.jpg (file) |  |
30 KB | Admin | 1 | |
| 18:45, 6 December 2024 | PKETc.jpg (file) |  |
41 KB | Admin | 1 | |
| 18:43, 6 December 2024 | PKSc.jpg (file) |  |
41 KB | Admin | 1 | |
| 18:42, 6 December 2024 | PKLTc.jpg (file) |  |
50 KB | Admin | 1 | |
| 18:35, 6 December 2024 | PMSc.jpg (file) |  |
60 KB | Admin | 1 | |
| 18:35, 6 December 2024 | PMLTc.jpg (file) |  |
58 KB | Admin | 1 | |
| 18:35, 6 December 2024 | PMETc.jpg (file) |  |
66 KB | Admin | 1 | |
| 18:27, 6 December 2024 | POSc.jpg (file) |  |
69 KB | Admin | 1 | |
| 18:26, 6 December 2024 | POLTc.jpg (file) |  |
67 KB | Admin | 1 | |
| 18:25, 6 December 2024 | POETc.jpg (file) |  |
58 KB | Admin | 1 | |
| 18:24, 6 December 2024 | PVSc.jpg (file) |  |
68 KB | Admin | 1 | |
| 18:24, 6 December 2024 | PVLTc.jpg (file) |  |
66 KB | Admin | 1 | |
| 18:23, 6 December 2024 | PVETc.jpg (file) |  |
67 KB | Admin | 1 |